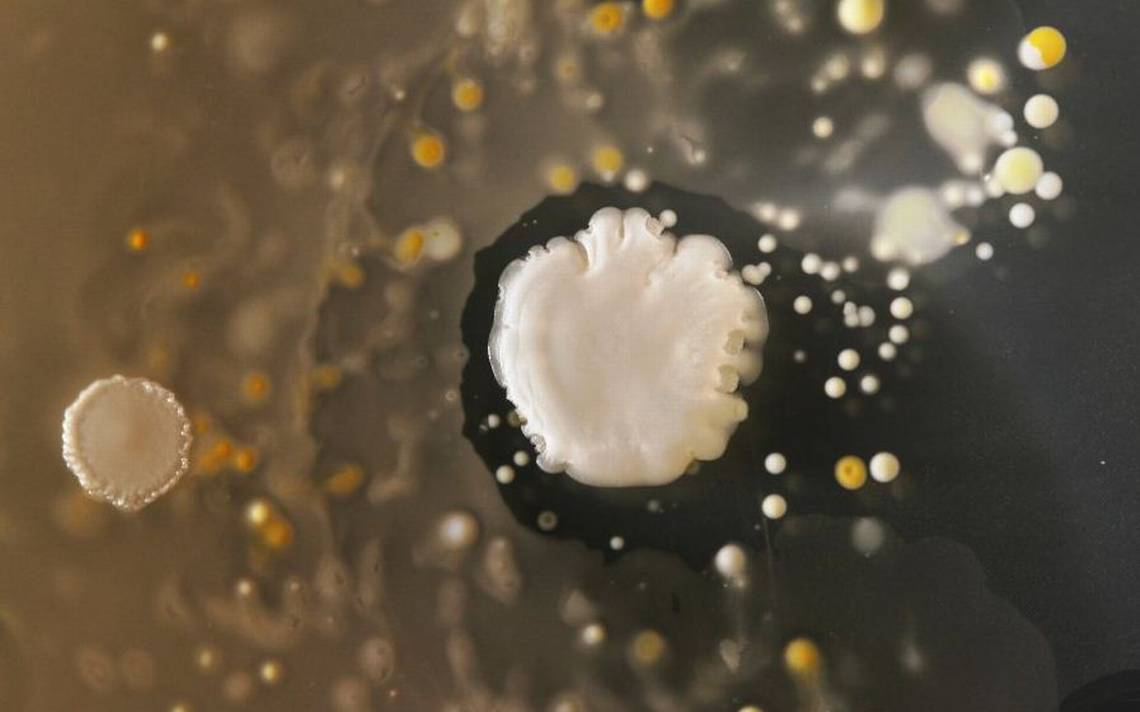
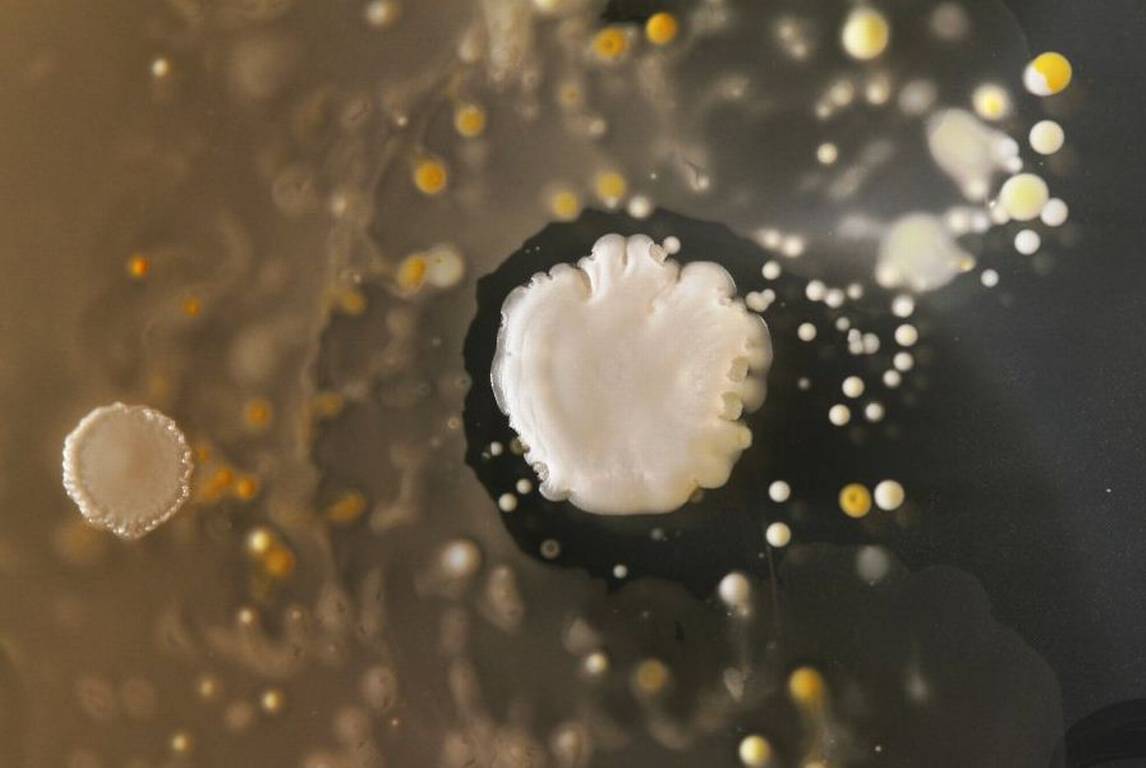
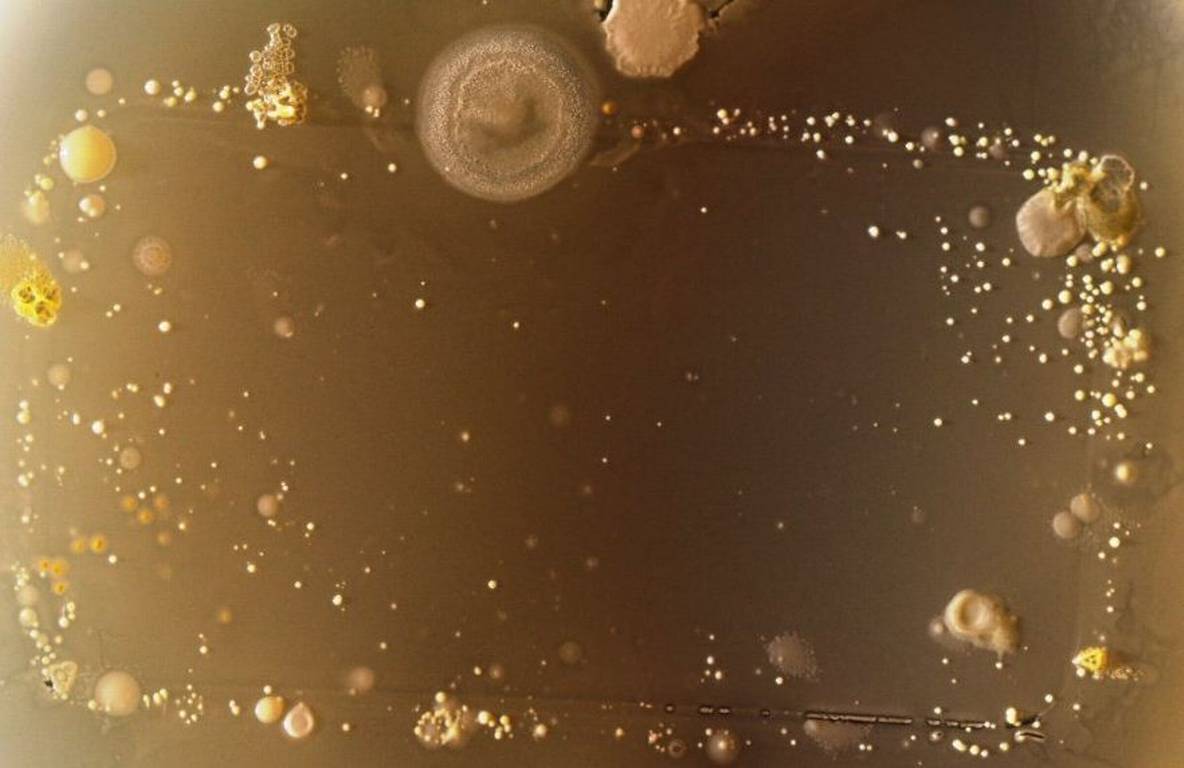
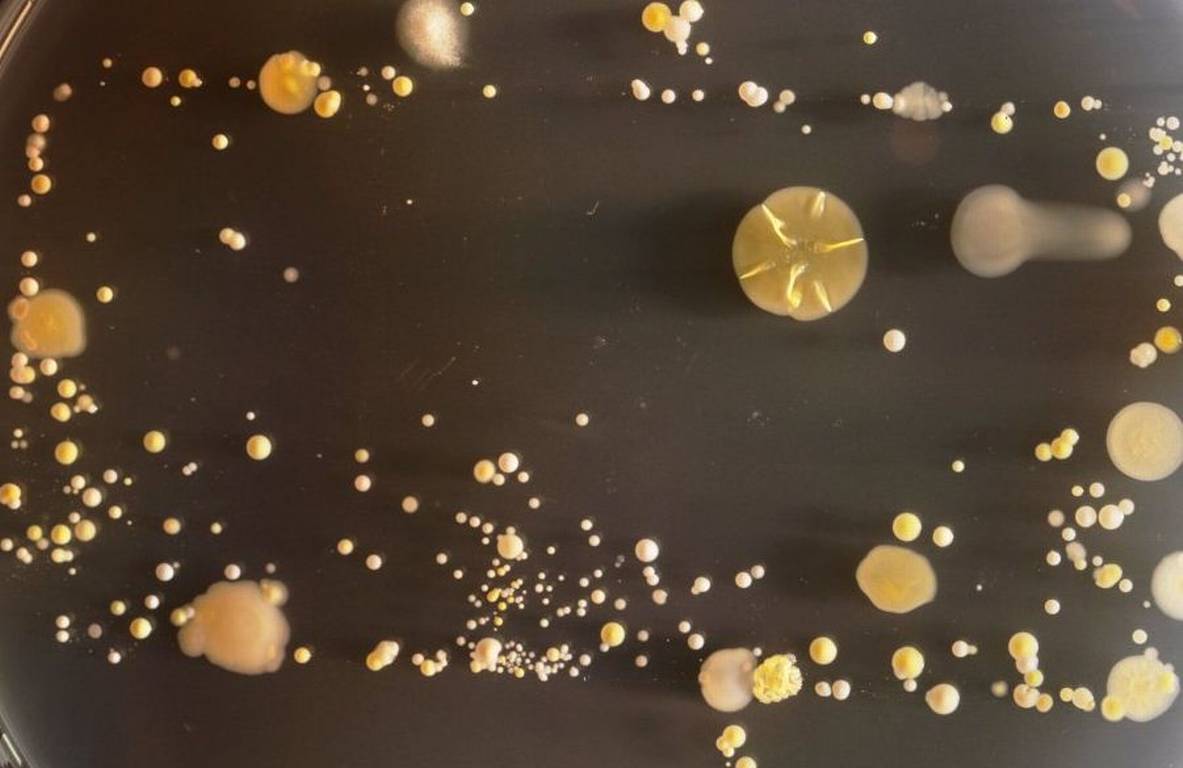

Parece que nuestro celular no sólo guarda la historia de nuestros contactos, y recuerda nuestras conversaciones y números de teléfono. También contiene una historia personal.
Tiene que ver con nuestro contacto físico con el teléfono, su relación con otras personas, el suelo o los lugares como bolsillos, encimeras o mesas de trabajo, donde lo dejamos. Todas ellas dejan un rastro en nuestro aparato, que se puede observar con mejor detalle al microscopio.
El experimento del Doctor Simon Park, de la Universidad de Surrey en el Reino Unido, muestra la cantidad de diminuta vida que contiene nuestro celular.
Luego de dejar un par de días los celulares en el laboratorio, todos ellos contenían distintas clases diferentes de bacterias y hongos. Estos organismos se extendían por zonas donde tenían un mayor alimento. La mayor parte son inofensivas, al igual que muchas de las bacterias que constantemente cubren nuestros cuerpos. Pero existen algunas capaces de causar enfermedades.
Pero no sólo los celulares contienen estos organismos vivos microscópicos. Su funda de almohada, su ropa, su asiento de retrete también contienen bacterias y hongos.